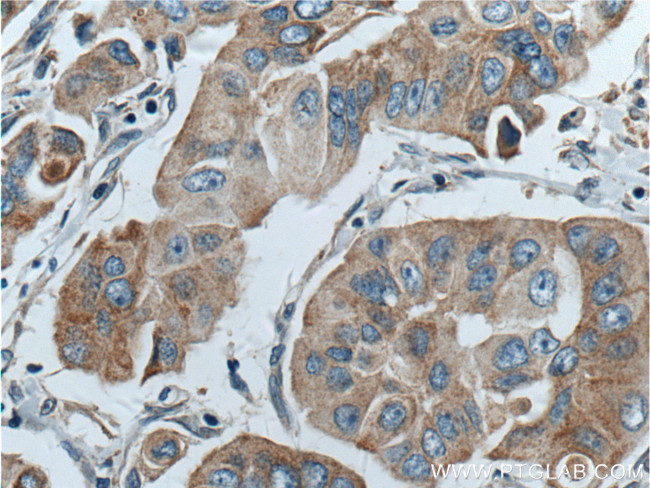
PLDN Antibody in Immunohistochemistry (Paraffin) (IHC (P))

Search
Proteintech
PLDN Polyclonal Antibody
{{$productOrderCtrl.translations['antibody.pdp.commerceCard.promotion.promotions']}}
{{$productOrderCtrl.translations['antibody.pdp.commerceCard.promotion.viewpromo']}}
{{$productOrderCtrl.translations['antibody.pdp.commerceCard.promotion.promocode']}}: {{promo.promoCode}} {{promo.promoTitle}} {{promo.promoDescription}}. {{$productOrderCtrl.translations['antibody.pdp.commerceCard.promotion.learnmore']}}









Please note: We are reviewing Western blot images included in the antibody testing data in our catalog, including those provided by third parties. Unless expressly labeled or annotated as “raw-unedited”, Western blot images included in the antibody testing data in our catalog may have been edited, optimized or otherwise adjusted for presentation.
产品信息
10891-2-AP
种属反应
已发表种属
宿主/亚型
分类
类型
抗原
偶联物
形式
浓度
规格
纯化类型
保存液
内含物
保存条件
运输条件
产品详细信息
Immunogen sequence: MSVPGPSSP DGALTRPPYC LEAGEPTPGL SDTSPDEGLI EDLTIEDKAV EQLAEGLLSH YLPDLQRSKQ ALQELTQNQV VLLDTLEQEI SKFKECHSML DINALFAEAK HYHAKLVNIR KEMLMLHEKT SKLKKRALKL QQKRQKEELE REQQREKEFE REKQLTARPA KRM (1-172 aa encoded by BC004819)
靶标信息
The aquaporins are a family of water-selective membrane channels. This gene encodes a member of a subset of aquaporins called the aquaglyceroporins. This protein allows passage of a broad range of noncharged solutes and also stimulates urea transport and osmotic water permeability. This protein may also facilitate the uptake of glycerol in hepatic tissue. The encoded protein may also play a role in specialized leukocyte functions such as immunological response and bactericidal activity. Alternate splicing results in multiple transcript variants.
仅用于科研。不用于诊断过程。未经明确授权不得转售。
生物信息学
蛋白别名: Biogenesis of lysosome-related organelles complex 1 subunit 6; biogenesis of organelles complex-1, subunit 6, pallidin; BLOC-1 subunit 6; Pallid protein; Pallid protein homolog; Pallidin; pallidin homolog; syntaxin 13 binding protein 1; Syntaxin 13-interacting protein; syntaxin 13-interacting protein pallid
基因别名: BLOC-1; BLOC1S6; P2; PA; PLDN; Stx13bp1
UniProt ID: (Rat) Q4V8A6, (Mouse) Q9R0C0
Entrez Gene ID: (Rat) 317630, (Mouse) 18457